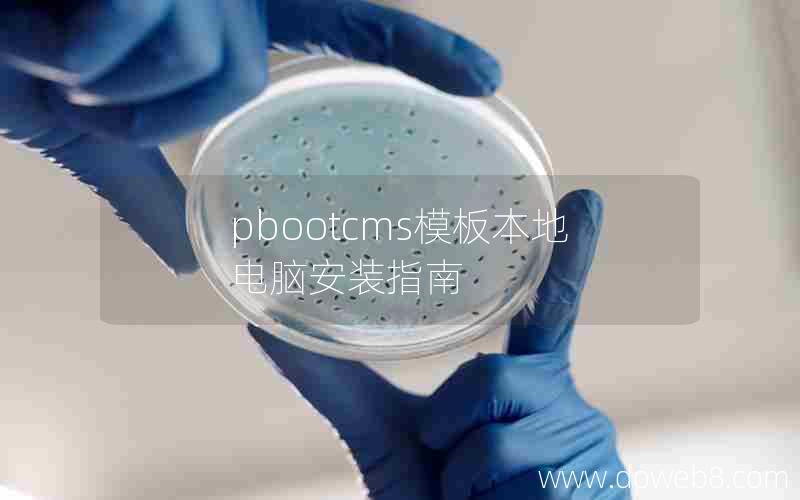

-

-

-

-

-

-

-

WordPress海外十大主机,哪个品牌的电脑主机好
WordPress海外十大主机WordPress是目前最受欢迎的网站建设平台之一,它的使用范围广泛,... -

WordPress关闭电脑访问,WordPress更换域名插件
WordPress关闭电脑访问WordPress是一个非常流行的博客和网站建设平台,但有时候我们需要... -

-
pbootcms模板本地电脑安装指南
“pbootcms模板本地电脑安装指南”是一篇详细介绍如何在本地电脑上安装pbootcms模板的实用... -

WordPress页面设置全屏,电脑怎么显示全屏模式
什么是WordPress页面全屏模式?WordPress页面全屏模式是指将页面内容展示在整个屏幕上,... -

阿里云LAMP安装WordPress,阿里云电脑
介绍随着互联网的发展,网站建设已经成为了一个非常重要的领域。而在网站建设中,选择一个合适的服务器和软... -

-





